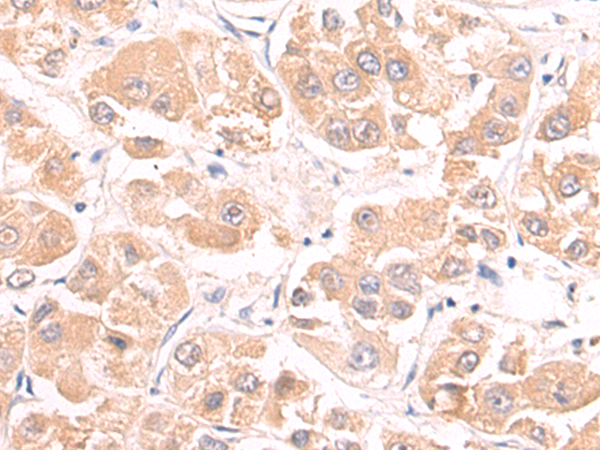

此商品无价格,无法添加至购物车内,系统已自动发起询价,
询价单号 点击跳转查看 X
询价单号 点击跳转查看 X

Order NO. D122689
兔抗MIER2多克隆抗体
编 号 | 规格 | 库存 | 目录价(¥) | 您的价格(¥) | 数 量 |
D122689-0025 | 25 ul | 现货 | 待询价 | 待询价 | |
D122689-0100 | 100 ul | 现货 | 待询价 | 待询价 | |
D122689-0200 | 200 ul | 现货 | 待询价 | 待询价 |
属性
Background: | Enables histone deacetylase binding activity. Contributes to histone deacetylase activity. Involved in histone deacetylation. Located in cytoplasm and nucleus. Part of protein-containing complex. (The background information is obtained from official databases and does not represent the product information.) |
Applications: | ELISA, WB, IHC |
Name of antibody: | MIER2 |
Immunogen: | Fusion protein of human MIER2 |
Full name: | MIER family member 2 |
Synonyms: | Mi-er2; KIAA1193 |
SwissProt: | Q8N344 |
ELISA Recommended dilution: | 5000-10000 |
IHC positive control: | Human liver cancer and Human thyroid cancer |
IHC Recommend dilution: | 50-200 |
WB Predicted band size: | 60 kDa |
WB Positive control: | HepG2, Jurkat, A549, C2C12 cell lysates |
WB Recommended dilution: | 1000-5000 |
选择结算方或PI
申请授权记录
申请授权

